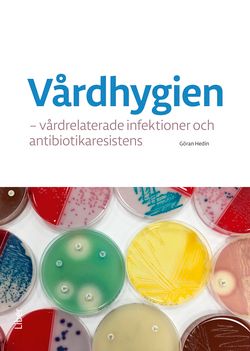
Vårdhygien - vårdrelaterade infektioner och antibiotikaresistens | 1:a upplagan

Vi flyttar från butik till nätet - så funkar det framåt
Vårdhygien - vårdrelaterade infektioner och antibiotikaresistens | 1:a upplagan
- Häftad, Svenska, 2020
- Författare: Göran Hedin
- Betyg:
Välj skick:
Skickas inom 2-5 vardagar
Skickas från säljare inom 1-3 vardagar
Ny säljare
Vill du sälja den här boken?
Sälj den här bokenBeskrivning
Läs mer
I boken beskrivs de mikroorganismer som orsakar vårdrelaterade infektioner, principer för antibiotikabehandling, antibiotikaresistenta bakterier, infektionsrisker vid olika typer av behandlingar och ingrepp, förebyggande åtgärder, hur smittspridning går till inom sjukvården, åtgärder för att förhindra smitta, rutiner som ska fungera – som till exempel städning, tvätthantering och desinfektion. Vidare görs en genomgång av hur smittskydd och vårdhygien är organiserat i Sverige, av lagar och förordningar, föreskrifter och allmänna råd och slutligen vart en patient som har synpunkter eller klagomål kan vända sig.
Boken riktar sig till studerande och yrkesverksamma inom hälso- och sjukvården. Den kan med fördel även läsas av beslutsfattare inom hälso- och sjukvården, journalister och allmänhet för att ge ökad kunskap på området.
Om denna bok
Vårdhygien - vårdrelaterade infektioner och antibiotikaresistens av Göran Hedin är en Häftad bok med 156 sidor på Svenska. Detta är den 1:a upplagan som utgavs 2020 av Liber AB.
Spara pengar – köp begagnad från Campusbokhandeln
Köp Vårdhygien - vårdrelaterade infektioner och antibiotikaresistens begagnad från Campusbokhandeln och spara upp till 28% jämfört med nypris. Begagnade exemplar finns från 324 kr medan nya kostar 448 kr – en besparing på 124 kr. Köp tryggt med Campusbokhandeln.
Genom att köpa & sälja begagnat sänker du kostnaden för studier både för dig och nästa student samtidigt som du gör nytta för klimatet.
Används vid svenska universitet
Denna kurslitteratur används aktivt i 11 universitetskurser vid lärosäten runt om i Sverige, inklusive:
- Göteborgs universitet: OMI100 , OMI110 , OMO101 , OMO110 , OMO120 , RAOM20 , OM4260 , RAOM21
- Uppsala universitet: 3SJ370 , 3SJ460
- Örebro universitet: MC037G
Boken är särskilt populär inom Medicin, vård & fysiologi-programmen.
Produktinformation